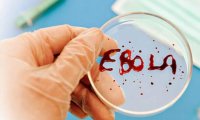
Анализы не выявили вируса Эболы у жителя Дальнего Востока

Пожар в здании ИНИОН РАН тушили сутки
Угроза обрушения здания библиотеки Института научной информации по общественным наукам (ИНИОН), пожар в котором был потушен 31 января поздно вечером, сохраняется, сообщает ГУ МЧС по Москве.

Угроза обрушения здания библиотеки Института научной информации по общественным наукам (ИНИОН), пожар в котором был потушен 31 января поздно вечером, сохраняется, сообщает ГУ МЧС по Москве.

В воскресенье с космодрома «Байконур» был произведен успешный запуск ракеты-носителя (РН) «Протон-М» с британским телекоммуникационным спутником «Инмарсат-5Ф2». Нынешний старт «Протона» – первый в...

Высокопоставленные американские чиновники и военные после новых поражений украинской армии вновь начали рассматривать возможность поставок Киеву оборонительных вооружений.

Японское правительство просит парламент изменить конституцию и разрешить использовать силы самообороны для защиты от террористов японских граждан за рубежом. Как заявил премьер-министр Синдзо Абэ,...
Пациент, у которого подозревали заболевание геммарагической лихорадкой Эбола, останется в стационаре Уссурийска до получения окончательных результатов анализов.

Популярная социальная сеть Facebook в будущем начнет активную борьбу с распространением фейковых новостей на своих страницах. Чтобы содержание новостей подверглось проверке, пользователям будет...

Знание нескольких иностранных языков способно замедлить процесс развития болезни Альцгеймера. Согласно результатам исследования, у полиглотов развитие данной болезни происходит на пять лет позже.

Многие полагают, что для создания уютной атмосферы, в доме должен витать аромат кофе или свежей выпечки. Тем не менее эксперты уверены: чтобы продать новое жилье, внутри должен чувствоваться запах...

Известный американский певец Джастин Тимберлейк подтвердил на своей страничке в социальной сети Instagram, что его жена, актриса Джессика Бил, ждет ребенка.

Режиссер российской картины «Левиафан», претендующей на кинопремию «Оскар» в номинации «Лучший иностранный фильм», посоветовал своим поклонникам скачать ленту в сети, если у них нет возможности...

Американские специалисты проведи исследование, которое подтвердило необходимость пополнения рациона питания человека оливковым маслом. Оказалось, что это продукт можно назвать наиболее ценной...

Существует масса распространенных обывательских заблуждений, связанных с медициной. Люди на самом деле в них верят и часто следуют самым нелепым советам.

Президент McDonald’s в России и Центральной Европе Хамзат Хасбулатов в ходе пресс-конференции, посвященной 25-летию работы компании в РФ, рассказал о результатах прошлого года и планах на текущий год.

Антикризисный план, предполагающий выделение более триллиона рублей, подвергся критике Минфина. Финансовое ведомство предлагает выделить на его реализацию не больше десяти миллиардов.

Разрушение металла остается проблемой для многих отраслей промышленности. Ученые Университета Манчестера предложили использовать для защиты металлов «графеновую краску» из оксида графена.

Новички биржевой торговли и просто азартные люди очень похожи по поведению с голубями. В момент выигрыша игрок охотно рискует ради получения еще большего выигрыша. Точно так же поступают голуби,...
Исследование ученых позволило выявить прямую связь между количеством друзей в социальной сети и объемом мозга. Чем больше «френдов» – тем крупнее мозг пользователя.